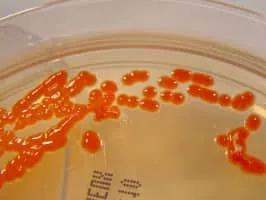
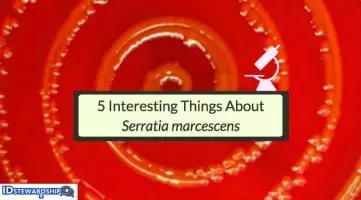
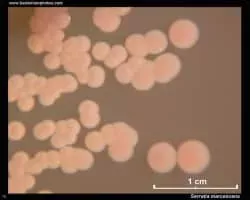

Serratia
| Use attributes for filter ! | |
| Family | Yersiniaceae |
|---|---|
| Phylum | Proteobacteria |
| Scientific name | Serratia |
| Order | Enterobacterales |
| Rank | Genus |
| Higher classification | Enterobacteriaceae |
| Lower classifications | Serratia marcescens |
| Serratia aquatilis | |
| Date of Reg. | |
| Date of Upd. | |
| ID | 2441298 |
About Serratia
Serratia is a genus of Gram-negative, facultatively anaerobic, rod-shaped bacteria of the family Yersiniaceae. They are typically 1–5 μm in length and do not produce spores.